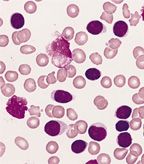

Monotherapy with the investigational oral Bruton's tyrosine kinase inhibitor ibrutinib was well tolerated and produced durable responses in a phase Ib/II, open-label, multicenter study of 85 patients with relapsed/refractory chronic lymphocytic leukemia or small lymphocytic lymphoma.
Monotherapy with the investigational, oral Bruton's tyrosine kinase (BTK) inhibitor ibrutinib was well tolerated and produced durable responses in a phase Ib/II, open-label, multicenter study of 85 patients with relapsed/refractory chronic lymphocytic leukemia (CLL) or small lymphocytic lymphoma (SLL). Findings were reported June 19 in the New England Journal of Medicine.
CLL:
Blood smear from an adult male with a marked lymphocytosis, Wright-Giemsa stain. Three damaged cells are present (click for full image). This morphology is characteristic of the majority of cases of B-cell CLL.
Primary endpoint was the safety of two fixed-dose regimens (assessed according to the frequency and severity of adverse events). Secondary endpoints were overall response rate, progression-free survival, pharmacodynamics, and pharmacokinetics. The data were presented in part at the annual meeting of the American Society of Hematology in December 2012. Promising results were achieved at both doses in patients with advanced disease and high-risk disease, defined by clinical or genetic features such as a deletion of part of chromosome 17 (del17p), often associated with a poor prognosis.
Patients with a confirmed diagnosis of relapsed/refractory CLL or SLL were enrolled at eight sites in the United States. Participants had a median of four prior therapies; 65% of patients had advanced disease and 35% of CLL patients had del17p. Patients were selected to receive ibrutinib, either 420 mg (n = 51) or 840 mg (n = 34), administered orally once daily.
Both doses were associated with overall response rates of 71%. Del17p patients had an overall response rate of 68%. Two patients in the 420 mg dose arm had complete responses and 34 patients had partial responses. Among all relapsed or refractory patients, including high-risk patients, estimated progression-free survival at 26 months was 75%, and 83% of patients were still alive. An additional 20% of patients treated with the 420 mg dose and 15% of patients who received the 840 mg dose achieved a partial response accompanied by asymptomatic lymphocytosis, which was transient and resolved with continued treatment with ibrutinib.
“The responses to ibrutinib that we observed in this study were more durable than expected on the basis of previous experience with other single-agent therapies for relapsed CLL,” said the investigators. “At both doses of ibrutinib, pharmacokinetic data showed rapid absorption and elimination. Moreover, pharmacodynamic data showed that once-daily ibrutinib provided effective and complete occupancy of BTK, a surrogate of kinase inhibition.”
Long-term therapy with ibrutinib was associated with “modest toxicity,” said the investigators. Most adverse events were grade 1 or 2 and included diarrhea, fatigue, and upper respiratory tract infection. Most resolved without need for suspension of treatment. (Six patients experienced an adverse event leading to discontinuation of ibrutinib.) The most common adverse events of grade 3 or higher were pneumonia in 10 patients (12%) and dehydration in 5 patients (6%). Infections of grade 3 or higher occurred most frequently early in the course of therapy and the average rate of grade 3 or higher infections was reduced by more than half after 6 months of treatment. Grade 3 or higher hematologic toxicities were not common.
“Patients with CLL and SLL have a great need for new, well-tolerated, and effective therapies,” said lead author John C. Byrd, MD, director of the division of hematology at the Ohio State University Comprehensive Cancer Center, Columbus, Ohio. “These data are particularly exciting, as they demonstrate benefit for high-risk CLL and SLL patients, with efficacy consistent across doses and continuing durable remissions lasting in excess of 2 years in the great majority of patients treated.”
“Ibrutinib is a first-in-class targeted inhibitor of BTK, which is showing remarkable activity in CLL, as seen in the data in this very nicely written NEJM article,” commented Jennifer R. Brown, MD, PhD, assistant professor of medicine, lymphoma program, Dana-Farber Cancer Institute, Boston. “It is a well-tolerated pill which is nonetheless able to control relapsed CLL for extended periods, even as a single agent and in at least some high-risk patients. The next few years in CLL research will be very exciting as we figure out how best to use this drug as well as other targeted inhibitors, for the maximum benefit of our patients.”
The study was supported by Pharmacyclics, Inc, which entered a collaboration and license agreement with Janssen Biotech, Inc, in December 2011 to co-develop and co-commercialize ibrutinib. Ibrutinib is currently being investigated for use in several B-cell malignancies.